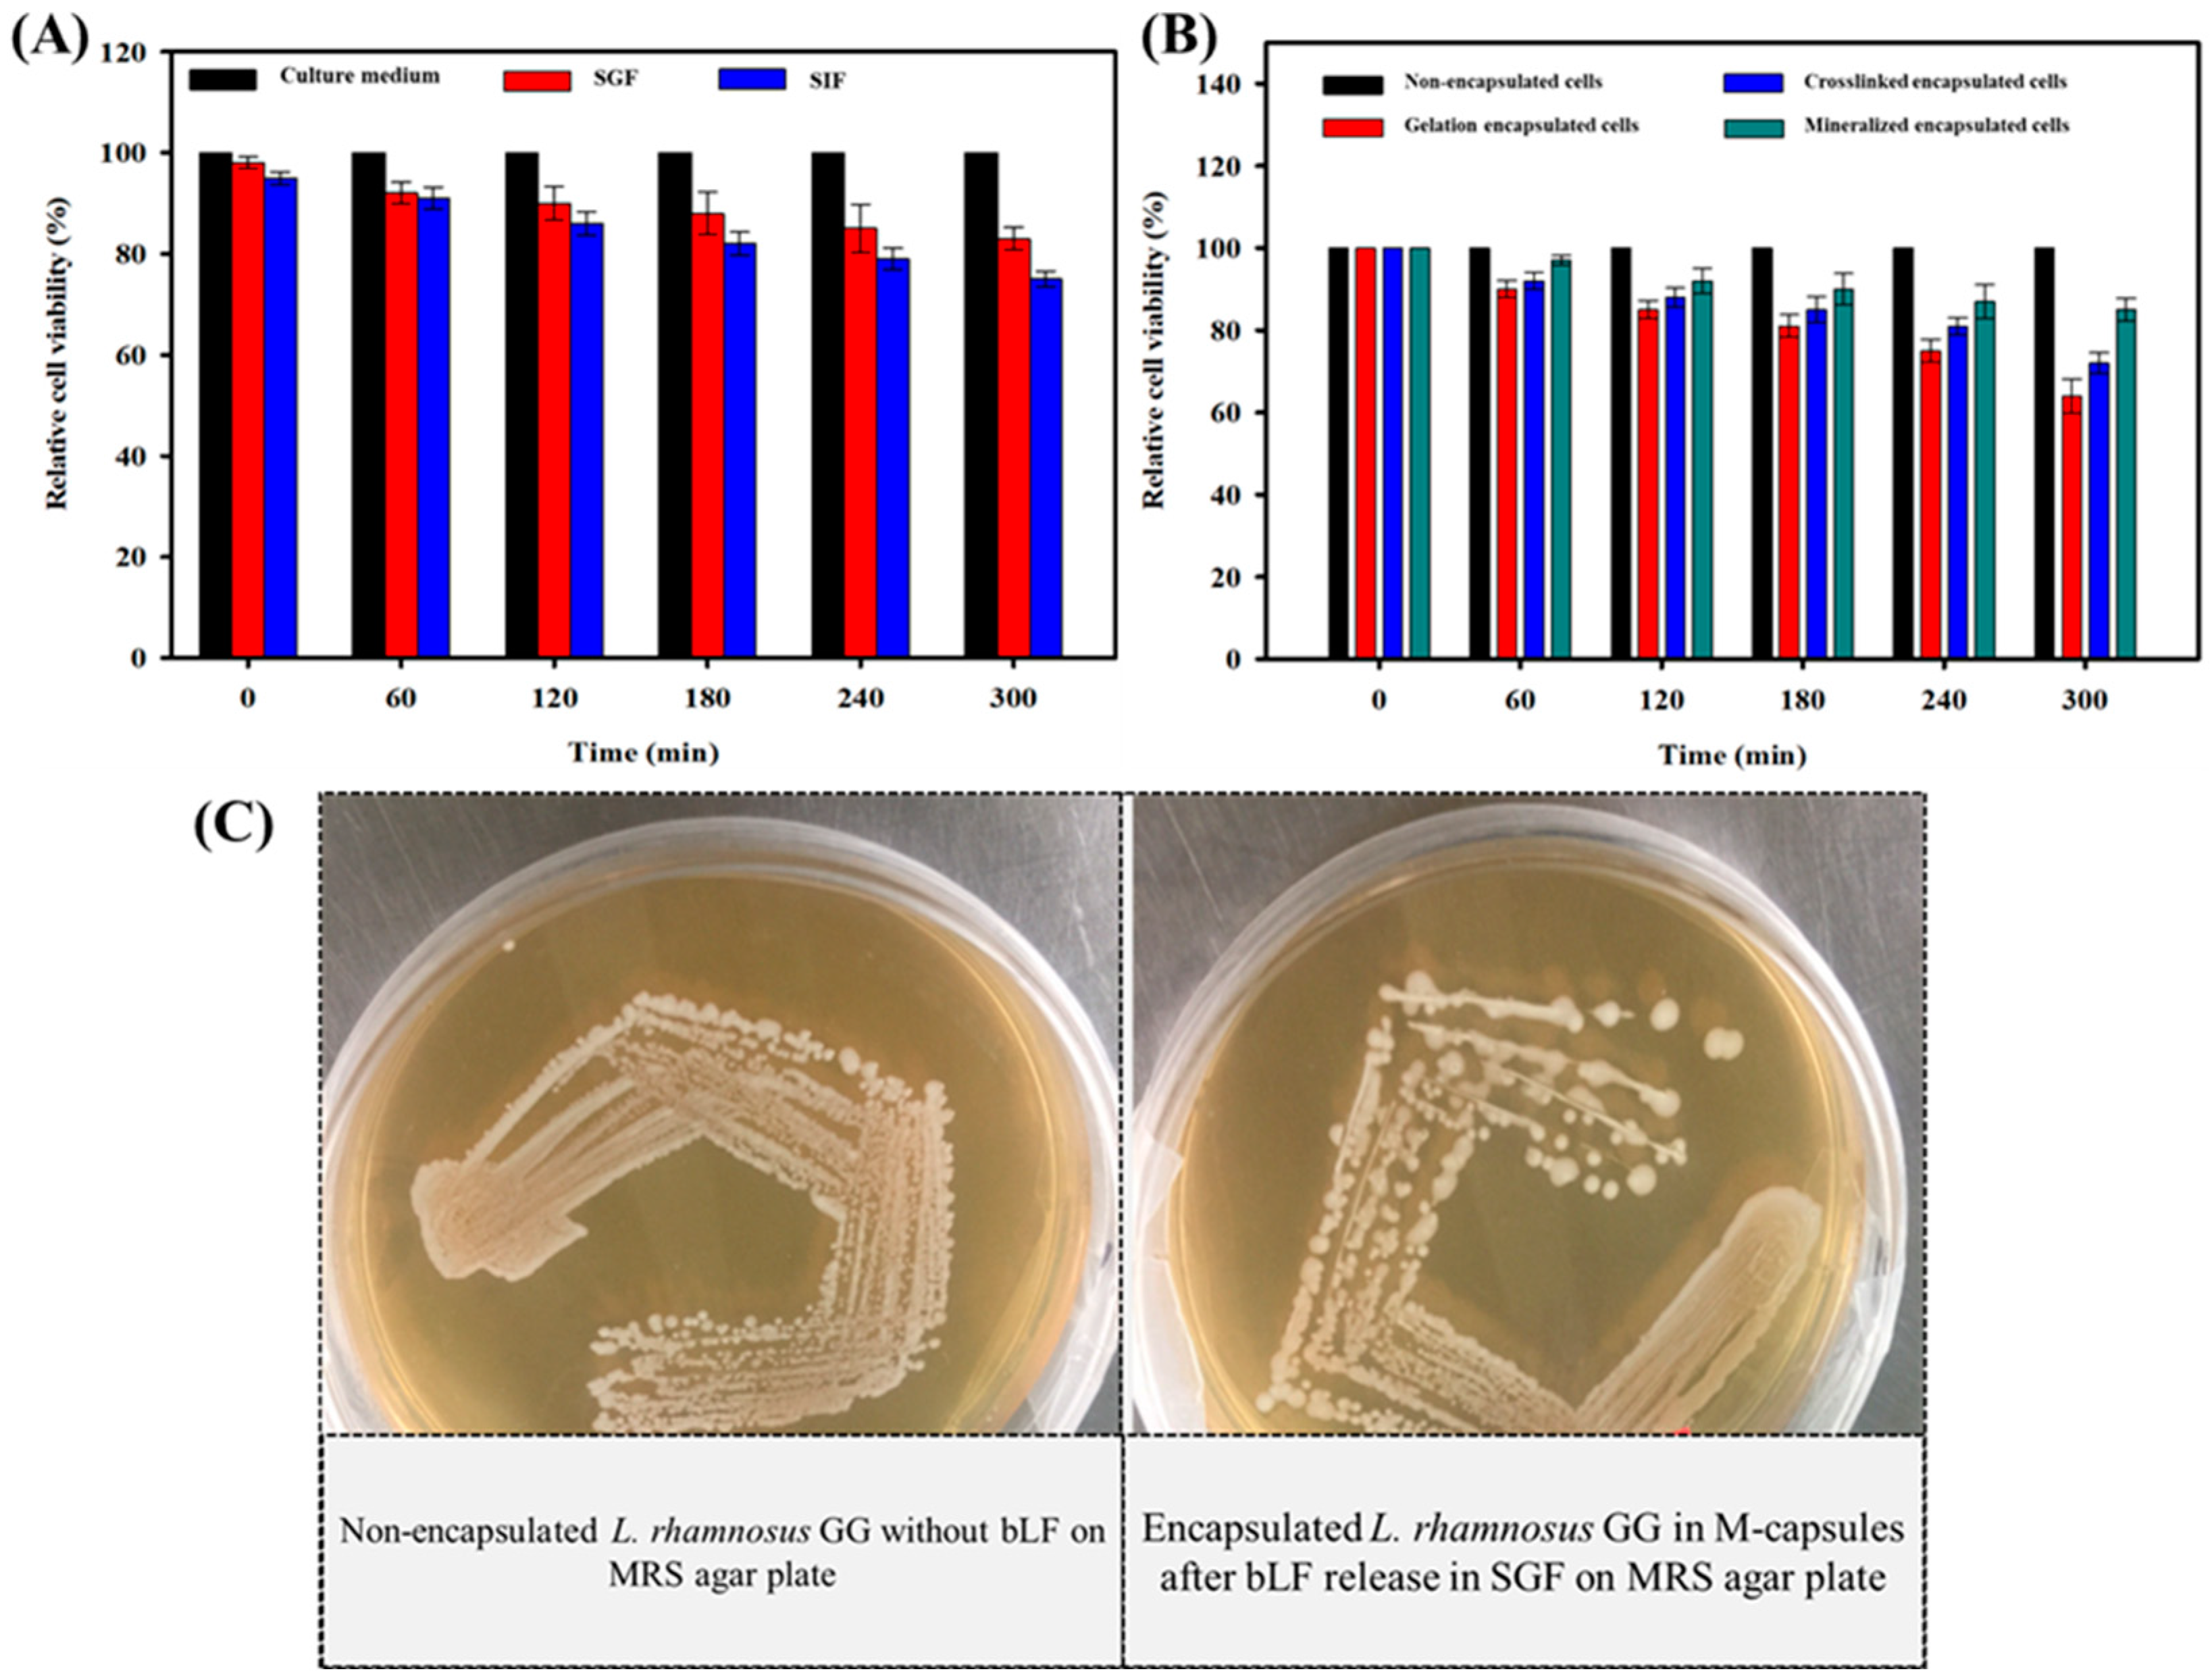
Biomimetics 07 00152 g005 Biomimetics 07 00152 g005

Microencapsulation of Lacticaseibacillus rhamnosus GG for Oral Delivery of Bovine Lactoferrin: Study of Encapsulation Stability, Cell Viability, and Drug Release
Abstract
1. Introduction
2. Materials and Methods
2.1. Materials
2.2. Preparation of SGF and SIF
2.3. Preparation and Characterization of Capsules
2.4. Swelling Behavior of Capsules
2.5. Culturing and Microencapsulation of L. rhamnosus GG
2.6. Entrapment of bLf on the Surface of Encapsulated L. rhamnosus GG, and Chemical Characterization
2.7. In Vitro bLf Release
2.8. Viability of L. rhamnosus GG after the Release of bLf
2.9. Statistical Analysis
3. Results
3.1. Formation, Structural Morphology, and Swelling Behavior of Capsules
3.2. Morphology of Encapsulated L. rhamnosus GG Cells
3.3. Viability of Microencapsulated L. rhamnosus GG Cells
3.4. Entrapment Efficiency and In Vitro Release of bLf from the Encapsulated L. rhamnosus GG Cells
4. Discussion
5. Conclusions
Author Contributions
Funding
Data Availability Statement
Conflicts of Interest
References
- Young, G. The bacteria diet. Nat. Rev. Microbiol. 2008, 6, 175. [Google Scholar] [CrossRef]
- Gareau, M.G.; Sherman, P.M.; Walker, W.A. Probiotics and the gut microbiota in intestinal health and disease. Nat. Rev. Gastroenterol. Hepatol. 2010, 7, 503–514. [Google Scholar] [CrossRef] [PubMed]
- Win, K.Y.; Feng, S.S. Effects of particle size and surface coating on cellular uptake of polymeric nanoparticles for oral delivery of anticancer drugs. Biomaterials 2005, 26, 2713–2722. [Google Scholar] [CrossRef] [PubMed]
- Roig-Sanchez, S.; Torrecilla, O.; Floriach-Clark, J.; Parets, S.; Levkin, P.A.; Roig, A.; Laromaine, A. One-Step Biosynthesis of Soft Magnetic Bacterial Cellulose Spheres with Localized Nanoparticle Functionalization. ACS Appl. Mater. Interfaces 2021, 13, 55569–55576. [Google Scholar] [CrossRef]
- Harush-Frenkel, O.; Rozentur, E.; Benita, S.; Altschuler, Y. Surface Charge of Nanoparticles Determines Their Endocytic and Transcytotic Pathway in Polarized MDCK Cells. Biomacromolecules 2008, 9, 435–443. [Google Scholar] [CrossRef] [PubMed]
- Sandri, G.; Bonferoni, M.C.; Rossi, S.; Ferrari, F.; Gibin, S.; Zambito, Y.; Di Colo, G.; Caramella, C. Nanoparticles based on N-trimethylchitosan: Evaluation of absorption properties using in vitro (Caco-2 cells) and ex vivo (excised rat jejunum) models. Eur. J. Pharm. Biopharm. 2007, 65, 68–77. [Google Scholar] [CrossRef] [PubMed]
- Chin, J.; Turner, B.; Barchia, I.; Mullbacher, A. Immune response to orally consumed antigens and probiotic bacteria. Immunol. Cell Biol. 2000, 78, 55–66. [Google Scholar] [CrossRef]
- Reuter, G. Probiotics—Possibilities and limitations of their application in food, animal feed, and in pharmaceutical preparations for men and animals. Berl. Munch. Tierarztl. Wochenschr. 2001, 114, 410–419. [Google Scholar]
- Donohue, D.C.; Salminen, S. Safety of Probiotic Bacteria. Asia. Pac. J. Clin. Nutr. 1996, 5, 25–28. [Google Scholar] [PubMed]
- Tripathi, M.K.; Giri, S.K. Probiotic functional foods: Survival of probiotics during processing and storage. J. Funct. Foods 2014, 9, 225–241. [Google Scholar] [CrossRef]
- Ullah, M.W.; Shi, Z.; Shi, X.; Zeng, D.; Li, S.; Yang, G. Microbes as Structural Templates in Biofabrication: Study of Surface Chemistry and Applications. ACS Sustain. Chem. Eng. 2017, 5, 11163–11175. [Google Scholar] [CrossRef]
- Kiprono, S.J.; Ullah, M.W.; Yang, G. Encapsulation of E. coli in biomimetic and Fe3O4-doped hydrogel: Structural and viability analyses. Appl. Microbiol. Biotechnol. 2017, 102, 933–944. [Google Scholar] [CrossRef]
- Jiménez-Pranteda, M.L.; Poncelet, D.; Náder-Macías, M.E.; Arcos, A.; Aguilera, M.; Monteoliva-Sánchez, M.; Ramos-Cormenzana, A. Stability of lactobacilli encapsulated in various microbial polymers. J. Biosci. Bioeng. 2012, 113, 179–184. [Google Scholar] [CrossRef]
- Khan, S.; Ullah, M.W.; Siddique, R.; Nabi, G.; Manan, S.; Yousaf, M.; Hou, H. Role of Recombinant DNA Technology to Improve Life. Int. J. Genom. 2016, 2016, 2405954. [Google Scholar] [CrossRef]
- Nguyen, T.D.; Guyot, S.; Lherminier, J.; Waché, Y.; Saurel, R.; Husson, F. Protection of living yeast cells by micro-organized shells of natural polyelectrolytes. Process Biochem. 2015, 50, 1528–1536. [Google Scholar] [CrossRef]
- Pouget, E.; Grelet, E. Dispersions of Monodisperse Hybrid Rod-Like Particles by Mineralization of Filamentous Viruses. Langmuir 2013, 29, 8010–8016. [Google Scholar] [CrossRef]
- Burgain, J.; Gaiani, C.; Linder, M.; Scher, J. Encapsulation of probiotic living cells: From laboratory scale to industrial applications. J. Food Eng. 2011, 104, 467–483. [Google Scholar] [CrossRef]
- Cook, M.T.; Tzortzis, G.; Charalampopoulos, D.; Khutoryanskiy, V.V. Production and Evaluation of Dry Alginate-Chitosan Microcapsules as an Enteric Delivery Vehicle for Probiotic Bacteria. Biomacromolecules 2011, 12, 2834–2840. [Google Scholar] [CrossRef] [PubMed]
- Panday, R.; Poudel, A.J.; Li, X.; Adhikari, M.; Ullah, M.W.; Yang, G. Amphiphilic core-shell nanoparticles: Synthesis, biophysical properties, and applications. Colloids Surf. B Biointerfaces 2018, 172, 68–81. [Google Scholar] [CrossRef] [PubMed]
- Kailasapathy, K. Microencapsulation for Gastrointestinal Delivery of Probiotic Bacteria. In Nano- and Microencapsulation for Foods; Hae-Soo, K., Ed.; John Wiley & Sons, Ltd.: Oxford, UK, 2014; pp. 167–197. [Google Scholar] [CrossRef]
- Chang, T.M.S. Semipermeable Microcapsules. Science 1964, 146, 524–525. [Google Scholar] [CrossRef]
- Prakash, S.; Chang, T. Microencapsulated genetically engineered live E. coli DH5 cells administered orally to maintain normal plasma urea level in uremic rats. Nat. Med. 1996, 2, 883–887. [Google Scholar] [CrossRef]
- Aljohani, W.J.; Li, W.; Ullah, M.W.; Zhang, X.; Yang, G. Application of Sodium Alginate Hydrogel. IOSR J. Biotechnol. Biochem. 2017, 3, 19–31. [Google Scholar] [CrossRef]
- Ullah, M.W.; Khattak, W.A.; Ul-Islam, M.; Khan, S.; Park, J.K. Encapsulated yeast cell-free system: A strategy for cost-effective and sustainable production of bio-ethanol in consecutive batches. Biotechnol. Bioprocess Eng. 2015, 20, 561–575. [Google Scholar] [CrossRef]
- Aljohani, W.; Ullah, M.W.; Zhang, X.; Yang, G. Bioprinting and its applications in tissue engineering and regenerative medicine. Int. J. Biol. Macromol. 2018, 107, 261–275. [Google Scholar] [CrossRef]
- Shi, X.; Shi, Z.; Wang, D.; Ullah, M.W.; Yang, G. Microbial Cells with a Fe3 O4 Doped Hydrogel Extracellular Matrix: Manipulation of Living Cells by Magnetic Stimulus. Macromol. Biosci. 2016, 16, 1506–1514. [Google Scholar] [CrossRef] [PubMed]
- Chen, C.-K.; Law, W.-C.; Aalinkeel, R.; Yu, Y.; Nair, B.; Wu, J.; Mahajan, S.; Reynolds, J.L.; Li, Y.; Lai, C.K.; et al. Biodegradable cationic polymeric nanocapsules for overcoming multidrug resistance and enabling drug–gene co-delivery to cancer cells. Nanoscale 2013, 6, 1567–1572. [Google Scholar] [CrossRef] [PubMed]
- Kiprono, S.J.; Ullah, M.W.; Yang, G. Surface engineering of microbial cells: Strategies and applications. Eng. Sci. 2018, 1, 33–45. [Google Scholar] [CrossRef]
- Panyam, J.; Labhasetwar, V. Biodegradable nanoparticles for drug and gene delivery to cells and tissue. Adv. Drug Deliv. Rev. 2012, 64, 61–71. [Google Scholar] [CrossRef]
- Soppimath, K.S.; Aminabhavi, T.M.; Kulkarni, A.R.; Rudzinski, W.E. Biodegradable polymeric nanoparticles as drug delivery devices. J. Control. Release 2001, 70, 1–20. [Google Scholar] [CrossRef]
- Zheng, J.; Wittouck, S.; Salvetti, E.; Franz, C.M.A.P.; Harris, H.M.B.; Mattarelli, P.; O’Toole, P.W.; Pot, B.; Vandamme, P.; Walter, J.; et al. A taxonomic note on the genus Lactobacillus: Description of 23 novel genera, emended description of the genus Lactobacillus Beijerinck 1901, and union of Lactobacillaceae and Leuconostocaceae. Int. J. Syst. Evol. Microbiol. 2020, 70, 2782–2858. [Google Scholar] [CrossRef]
- Xavier-Santos, D.; Scharlack, N.K.; Pena, F.D.L.; Antunes, A.E.C. Effects of Lacticaseibacillus rhamnosus GG supplementation, via food and non-food matrices, on children’s health promotion: A scoping review. Food Res. Int. 2022, 158, 111518. [Google Scholar] [CrossRef]
- Zhang, Y.; Cao, J.; Wang, X.; Liu, H.; Shao, Y.; Chu, C.; Xue, F.; Bai, J. The effect of enzymes on the in vitro degradation behavior of Mg alloy wires in simulated gastric fluid and intestinal fluid. Bioact. Mater. 2021, 7, 217–226. [Google Scholar] [CrossRef] [PubMed]
- Ullah, M.W.; Khattak, W.A.; Ul-Islam, M.; Khan, S.; Park, J.K. Bio-ethanol production through simultaneous saccharification and fermentation using an encapsulated reconstituted cell-free enzyme system. Biochem. Eng. J. 2014, 91, 110–119. [Google Scholar] [CrossRef]
- Nualkaekul, S.; Cook, M.T.; Khutoryanskiy, V.V.; Charalampopoulos, D. Influence of encapsulation and coating materials on the survival of Lactobacillus plantarum and Bifidobacterium longum in fruit juices. Food Res. Int. 2013, 53, 304–311. [Google Scholar] [CrossRef]
- Draget, K.I.; Skjåk Bræk, G.; Smidsrød, O. Alginic acid gels: The effect of alginate chemical composition and molecular weight. Carbohydr. Polym. 1994, 25, 31–38. [Google Scholar] [CrossRef]
- Andriamanantoanina, H.; Rinaudo, M. Relationship between the molecular structure of alginates and their gelation in acidic conditions. Polym. Int. 2010, 59, 1531–1541. [Google Scholar] [CrossRef]
- Uçar, G.; Uçar, M.B. The Estimation of Acidic Behavior of Wood by Treatment with Aqueous Na2HPO4 Solution. J. Anal. Methods Chem. 2012, 2012, 496305. [Google Scholar] [CrossRef]
- Wang, B.; Liu, P.; Jiang, W.; Pan, H.; Xu, X.; Tang, R. Yeast Cells with an Artificial Mineral Shell: Protection and Modification of Living Cells by Biomimetic Mineralization. Angew. Chem. Int. Ed. 2008, 47, 3560–3564. [Google Scholar] [CrossRef]
- Fakhrullin, R.F.; Shlykova, L.V.; Zamaleeva, A.I.; Nurgaliev, D.K.; Osin, Y.N.; García-Alonso, J.; Paunov, V.N. Interfacing Living Unicellular Algae Cells with Biocompatible Polyelectrolyte-Stabilised Magnetic Nanoparticles. Macromol. Biosci. 2010, 10, 1257–1264. [Google Scholar] [CrossRef]
- Gbassi, G.K.; Vandamme, T.; Ennahar, S.; Marchioni, E. Microencapsulation of Lactobacillus plantarum spp in an alginate matrix coated with whey proteins. Int. J. Food Microbiol. 2009, 129, 103–105. [Google Scholar] [CrossRef]
- Daemi, H.; Barikani, M. Synthesis and characterization of calcium alginate nanoparticles, sodium homopolymannuronate salt and its calcium nanoparticles. Sci. Iran. 2012, 19, 2023–2028. [Google Scholar] [CrossRef]
- Al-Sabah, A.; Burnell, S.E.A.; Simoes, I.N.; Jessop, Z.; Badiei, N.; Blain, E.; Whitaker, I.S. Structural and mechanical characterization of crosslinked and sterilised nanocellulose-based hydrogels for cartilage tissue engineering. Carbohydr. Polym. 2019, 212, 242–251. [Google Scholar] [CrossRef]
- Carta, D.; Pickup, D.M.; Knowles, J.C.; Ahmed, I.; Smith, M.E.; Newport, R.J. A structural study of sol–gel and melt-quenched phosphate-based glasses. J. Non-Cryst. Solids 2007, 353, 1759–1765. [Google Scholar] [CrossRef]
- Yao, X.; Bunt, C.; Cornish, J.; Quek, S.-Y.; Wen, J. Preparation, Optimization and Characterization of Bovine Lactoferrin-loaded Liposomes and Solid Lipid Particles Modified by Hydrophilic Polymers Using Factorial Design. Chem. Biol. Drug Des. 2014, 83, 560–575. [Google Scholar] [CrossRef]
- Śpiewak, K.; Majka, G.; Pilarczyk-Żurek, M.; Nowak, P.; Woźniakiewicz, M.; Pietrzyk, P.; Korzeniak, T.; Stochel-Gaudyn, A.; Fyderek, K.; Strus, M.; et al. Mn3+-saturated bovine lactoferrin as a new complex with potential prebiotic activities for dysbiosis treatment and prevention—On the synthesis, chemical characterization and origin of biological activity. J. Funct. Foods 2017, 38, 264–272. [Google Scholar] [CrossRef]
- Ansary, R.H.; Rahman, M.M.; Awang, M.B.; Katas, H.; Hadi, H.; Mohamed, F.; Doolaanea, A.A.; Kamaruzzaman, Y.B. Preparation, characterization and in vitro release study of BSA-loaded double-walled glucose-poly(lactide-co-glycolide) microspheres. Arch. Pharmacal Res. 2016, 39, 1242–1256. [Google Scholar] [CrossRef]
- Krstonošić, V.; Milanović, M.; Dokić, L. Application of different techniques in the determination of xanthan gum-SDS and xanthan gum-Tween 80 interaction. Food Hydrocoll. 2018, 87, 108–118. [Google Scholar] [CrossRef]
- Ullah, M.W.; Khattak, W.A.; Ul-Islam, M.; Khan, S.; Park, J.K. Metabolic engineering of synthetic cell-free systems: Strategies and applications. Biochem. Eng. J. 2016, 105, 391–405. [Google Scholar] [CrossRef]
- Blandino, A.; Macías, M.; Cantero, D. Glucose oxidase release from calcium alginate gel capsules. Enzym. Microb. Technol. 2000, 27, 319–324. [Google Scholar] [CrossRef]
- Bieber, T.; Meissner, W.; Kostin, S.; Niemann, A.; Elsasser, H.-P. Intracellular route and transcriptional competence of polyethylenimine–DNA complexes. J. Control. Release 2002, 82, 441–454. [Google Scholar] [CrossRef]
- Hillberg, A.L.; Oudshoorn, M.; Lam, J.B.B.; Kathirgamanathan, K. Encapsulation of porcine pancreatic islets within an immunoprotective capsule comprising methacrylated glycol chitosan and alginate. J. Biomed. Mater. Res. Part B Appl. Biomater. 2014, 103, 503–518. [Google Scholar] [CrossRef]
- Anirudhan, T.S.; Chithra Sekhar, V.; Shainy, F.; Jefin, P.T. Effect of dual stimuli responsive dextran/nanocellulose polyelectrolyte complexes for chemophotothermal synergistic cancer therapy. Int. J. Biol. Macromol. 2019, 135, 776–789. [Google Scholar] [CrossRef]
- Ding, W.K.; Shah, N.P. An Improved Method of Microencapsulation of Probiotic Bacteria for Their Stability in Acidic and Bile Conditions during Storage. J. Food Sci. 2009, 74, M53–M61. [Google Scholar] [CrossRef] [PubMed]
- Guimarães, A.; Abrunhosa, L.; Pastrana, L.M.; Cerqueira, M.A. Edible Films and Coatings as Carriers of Living Microorganisms: A New Strategy Towards Biopreservation and Healthier Foods. Compr. Rev. Food Sci. Food Saf. 2018, 17, 594–614. [Google Scholar] [CrossRef] [PubMed]
- Xiao, Y.; Lu, C.; Liu, Y.; Kong, L.; Bai, H.; Mu, H.; Li, Z.; Geng, H.; Duan, J. Encapsulation of Lactobacillus rhamnosus in Hyaluronic Acid-Based Hydrogel for Pathogen-Targeted Delivery to Ameliorate Enteritis. ACS Appl. Mater. Interfaces 2020, 12, 36967–36977. [Google Scholar] [CrossRef]
- Solanki, H.K.; Pawar, D.D.; Shah, D.A.; Prajapati, V.D.; Jani, G.K.; Mulla, A.M.; Thakar, P.M. Development of Microencapsulation Delivery System for Long-Term Preservation of Probiotics as Biotherapeutics Agent. BioMed Res. Int. 2013, 2013, 620719. [Google Scholar] [CrossRef]
- Gu, Z.; Biswas, A.; Zhao, M.; Tang, Y. Tailoring nanocarriers for intracellular protein delivery. Chem. Soc. Rev. 2011, 40, 3638–3655. [Google Scholar] [CrossRef]
- Sun, J.; Tan, H. Alginate-Based Biomaterials for Regenerative Medicine Applications. Materials 2013, 6, 1285–1309. [Google Scholar] [CrossRef]
- Sajjad, W.; He, F.; Ullah, M.W.; Ikram, M.; Shah, S.M.; Khan, R.; Khan, T.; Khalid, A.; Yang, G.; Wahid, F. Fabrication of Bacterial Cellulose-Curcumin Nanocomposite as a Novel Dressing for Partial Thickness Skin Burn. Front. Bioeng. Biotechnol. 2020, 8, 553037. [Google Scholar] [CrossRef] [PubMed]
- Li, S.; Jasim, A.; Zhao, W.; Fu, L.; Ullah, M.W.; Shi, Z.; Yang, G. Fabrication of pH-electroactive Bacterial Cellulose/Polyaniline Hydrogel for the Development of a Controlled Drug Release System. ES Mater. Manuf. 2018, 2018, 41–49. [Google Scholar] [CrossRef]
- Li, X.; Ji, X.; Chen, K.; Ullah, M.W.; Li, B.; Cao, J.; Xiao, L.; Xiao, J.; Yang, G. Immobilized thrombin on X-ray radiopaque polyvinyl alcohol/chitosan embolic microspheres for precise localization and topical blood coagulation. Bioact. Mater. 2021, 6, 2105–2119. [Google Scholar] [CrossRef]
- Pacheco-Quito, E.-M.; Ruiz-Caro, R.; Veiga, M.-D. Carrageenan: Drug Delivery Systems and Other Biomedical Applications. Mar. Drugs 2020, 18, 583. [Google Scholar] [CrossRef] [PubMed]
- Li, X.; Ji, X.; Chen, K.; Yuan, X.; Lei, Z.; Ullah, M.W.; Xiao, J.; Yang, G. Preparation and evaluation of ion-exchange porous polyvinyl alcohol microspheres as a potential drug delivery embolization system. Mater. Sci. Eng. C 2021, 121, 111889. [Google Scholar] [CrossRef] [PubMed]
- Liu, L.-S.; Liu, S.-Q.; Ng, S.Y.; Froix, M.; Ohno, T.; Heller, J. Controlled release of interleukin-2 for tumour immunotherapy using alginate/chitosan porous microspheres. J. Control. Release 1997, 43, 65–74. [Google Scholar] [CrossRef]

| Samples | Capsule Size (mm) | Entrapment Efficiency (%) | |
|---|---|---|---|
| Before Drug Loading | After Drug Loading | ||
| bLf-entrapped gelation-encapsulated cells | 3.20 ± 0.22 | 3.41 ± 0.22 | 78 ± 2.25 |
| bLf-entrapped crosslinking-encapsulated cells | 3.25 ± 0.31 | 3.43 ± 0.18 | 88 ± 1.78 |
| bLf-entrapped mineralization-encapsulated cells | 3.38 ± 0.35 | 3.61 ± 0.45 | 95 ± 1.12 |
Publisher’s Note: MDPI stays neutral with regard to jurisdictional claims in published maps and institutional affiliations. |
© 2022 by the authors. Licensee MDPI, Basel, Switzerland. This article is an open access article distributed under the terms and conditions of the Creative Commons Attribution (CC BY) license (https://creativecommons.org/licenses/by/4.0/).
Share and Cite
Anwar, Y.; Ullah, I.; Kamal, T.; Ullah, M.W. Microencapsulation of Lacticaseibacillus rhamnosus GG for Oral Delivery of Bovine Lactoferrin: Study of Encapsulation Stability, Cell Viability, and Drug Release. Biomimetics 2022, 7, 152. https://doi.org/10.3390/biomimetics7040152
Anwar Y, Ullah I, Kamal T, Ullah MW. Microencapsulation of Lacticaseibacillus rhamnosus GG for Oral Delivery of Bovine Lactoferrin: Study of Encapsulation Stability, Cell Viability, and Drug Release. Biomimetics. 2022; 7(4):152. https://doi.org/10.3390/biomimetics7040152
Chicago/Turabian StyleAnwar, Yasir, Ihsan Ullah, Tahseen Kamal, and Muhammad Wajid Ullah. 2022. "Microencapsulation of Lacticaseibacillus rhamnosus GG for Oral Delivery of Bovine Lactoferrin: Study of Encapsulation Stability, Cell Viability, and Drug Release" Biomimetics 7, no. 4: 152. https://doi.org/10.3390/biomimetics7040152
APA StyleAnwar, Y., Ullah, I., Kamal, T., & Ullah, M. W. (2022). Microencapsulation of Lacticaseibacillus rhamnosus GG for Oral Delivery of Bovine Lactoferrin: Study of Encapsulation Stability, Cell Viability, and Drug Release. Biomimetics, 7(4), 152. https://doi.org/10.3390/biomimetics7040152

